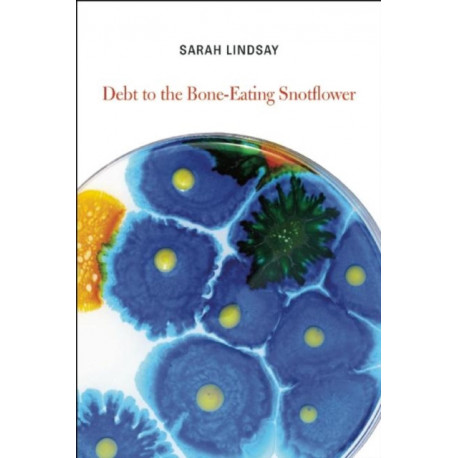

Kurv
Vare
varer
(tom)
Ingen varer
Fastlægges senere
Forsendelse
0,- kr
I alt
Debt to the Bone-Eating Snotflower
(Bog, Paperback / softback, Engelsk)
Forlag:
Copper Canyon Press,U.S.
- Type: Bog
- Format: Paperback / softback
-
Sprog:
Engelsk

- ISBN-13: 9781556594465
- Se flere detaljer ▼
Bemærk: Kan ikke leveres før jul.
Læsernes anmeldelser (0)
Alle detaljer
| Forlag | Copper Canyon Press,U.S. |
| Forfatter | Sarah Lindsay |
| Type | Bog |
| Format | Paperback / softback |
| Sprog | Engelsk |
| Udgivelsesdato | 16-01-2014 |
| Første udgivelsesår | 2014 |
| Originalsprog | United States |
| Sideantal | 88 |
| Indbinding | Paperback / softback |
| Forlag | Copper Canyon Press,U.S. |
| Sideoplysninger | 88 pages |
| Mål | 153 x 227 x 12 |
| ISBN-13 / EAN-13 | 9781556594465 |

